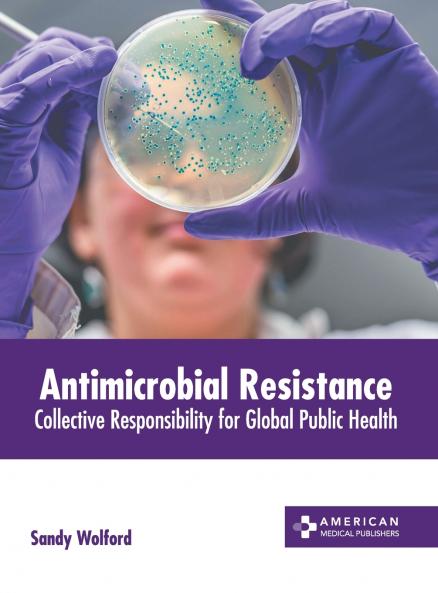
Antimicrobial Resistance

English
Hardback
₹13992
₹17338
19.3% OFF
(All inclusive*)
Delivery Options
Please enter pincode to check delivery time.
*COD & Shipping Charges may apply on certain items.
Review final details at checkout.
Looking to place a bulk order? SUBMIT DETAILS
Delivery Options
Please enter pincode to check delivery time.
*COD & Shipping Charges may apply on certain items.
Review final details at checkout.
About The Book
Description
Author
Antimicrobials are the medicines used to prevent and treat infections in humans animals and plants. Antimicrobial resistance (AMR) occurs when microbes such as bacteria viruses fungi and parasites alter over a period of time in such a way that they no longer respond to medicines which makes it difficult to treat the infections. This increases the risk of spreading of diseases severe illness and death. The rapid increase and spread of drug-resistant pathogens that have attained new resistance mechanisms leading to antimicrobial resistance continues to endanger the potential of antimicrobials to cure common infections. Especially alarming is the emergence and spread of multi- and pan-resistant bacteria also known as 'superbugs'. These cause infections that are not treatable with prevailing antimicrobial medicines such as antibiotics. Adequate investment and innovation is required in operational research and development of new antimicrobial medicines and vaccines in order to target antimicrobial resistance. This book provides comprehensive insights with respect to antimicrobial resistance. It will serve as a reference to a broad spectrum of readers.
Details
ISBN 13
9781639278848
Publication Date
-19-09-2023
Pages
-248
Weight
-745 grams
Dimensions
-216x280x15.88 mm